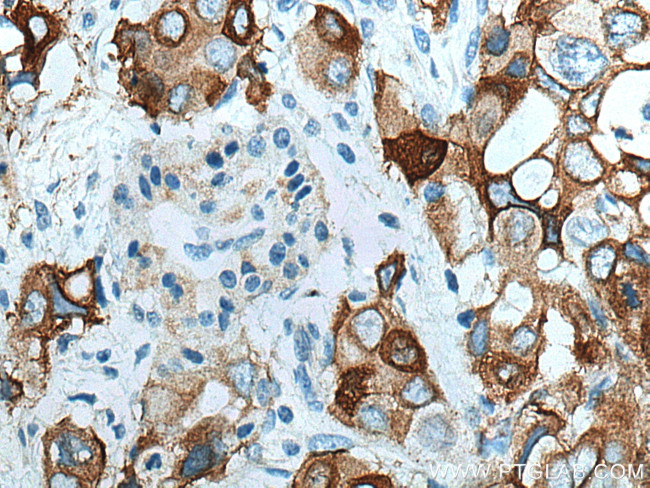
Integrin beta-4 Antibody in Immunohistochemistry (Paraffin) (IHC (P))

Search
Proteintech
Integrin beta-4 Polyclonal Antibody
{{$productOrderCtrl.translations['antibody.pdp.commerceCard.promotion.promotions']}}
{{$productOrderCtrl.translations['antibody.pdp.commerceCard.promotion.viewpromo']}}
{{$productOrderCtrl.translations['antibody.pdp.commerceCard.promotion.promocode']}}: {{promo.promoCode}} {{promo.promoTitle}} {{promo.promoDescription}}. {{$productOrderCtrl.translations['antibody.pdp.commerceCard.promotion.learnmore']}}
图: 1 / 12
Integrin beta-4 Antibody (21738-1-AP) in IHC (P)












产品信息
21738-1-AP
种属反应
已发表种属
宿主/亚型
分类
类型
抗原
偶联物
形式
浓度
规格
纯化类型
保存液
内含物
保存条件
运输条件
产品详细信息
Immunogen sequence: ANRCKKAPV KSCTECVRVD KDCAYCTDEM FRDRRCNTQA ELLAAGCQRE SIVVMESSFQ ITEETQIDTT LRRSQMSPQG LRVRLRPGEE RHFELEVFEP LESPVDLYIL MDFSNSMSDD LDNLKKMGQN LARVLSQLTS DYTIGFGKFV DKVSVPQTDM RPEKLKEPWP NSDPPFSFKN VISLTEDVDE FRNKLQGERI SGNLDAPEGG FDAILQTAVC TRDIGWRPDS THLLVFSTES AFHYEADGAN VLAGIMSRND ERCHLDTTGT YTQYRTQDYP SVPTLVRLLA KHNIIPIFAV TNYSYSYYEK LHTYFPVSSL GVLQEDSSN (27-354 aa encoded by BC126411)
靶标信息
Integrins are heterodimers comprised of alpha and beta subunits, that are noncovalently associated transmembrane glycoprotein receptors. Different combinations of alpha and beta polypeptides form complexes that vary in their ligand-binding specificities. Integrins mediate cell-matrix or cell-cell adhesion, and transduced signals that regulate gene expression and cell growth. This gene encodes the integrin beta 4 subunit, a receptor for the laminins. This subunit tends to associate with alpha 6 subunit and is likely to play a pivotal role in the biology of invasive carcinoma. Mutations in this gene are associated with epidermolysis bullosa with pyloric atresia. Multiple alternatively spliced transcript variants encoding distinct isoforms have been found for this gene.
仅用于科研。不用于诊断过程。未经明确授权不得转售。
生物信息学
蛋白别名: CD antigen CD104; CD104; CD104 antigen; GP150; Integrin beta-4; unnamed protein product
基因别名: AA407042; C230078O20; CD104; GP150; ITGB4; JEB5A; JEB5B
UniProt ID: (Human) P16144, (Mouse) A2A863, (Rat) Q64632
Entrez Gene ID: (Human) 3691, (Mouse) 192897, (Rat) 25724